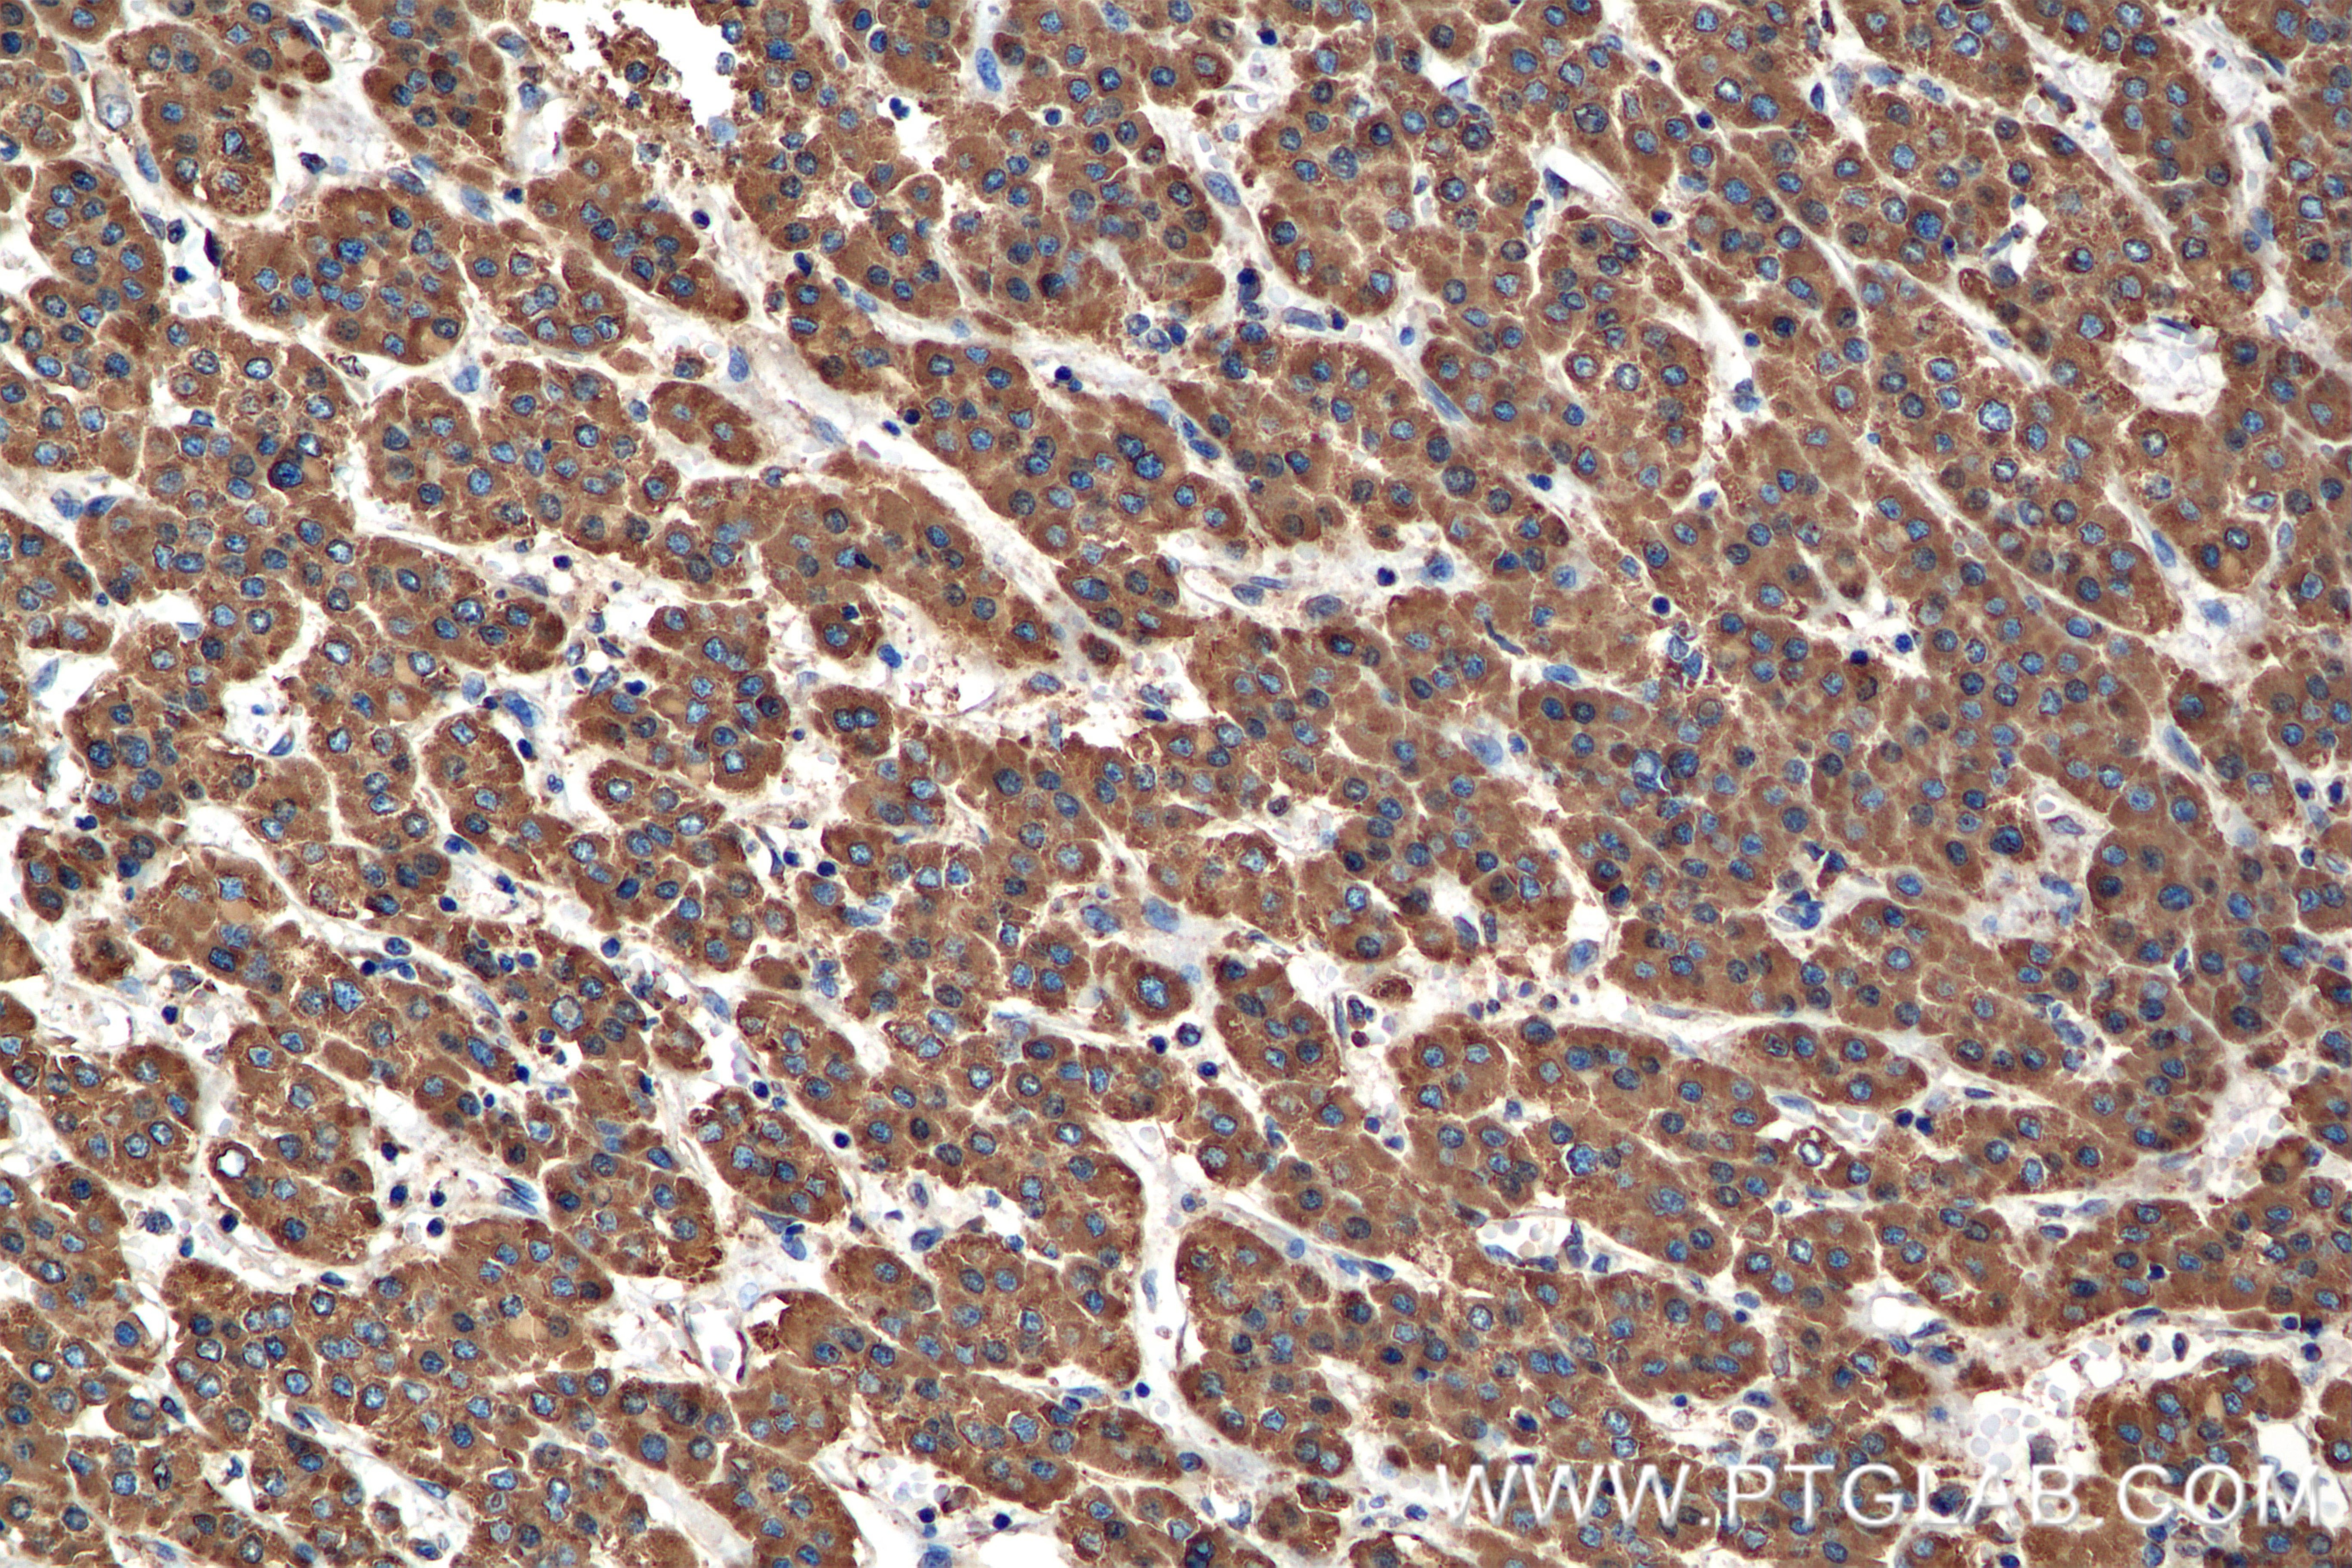
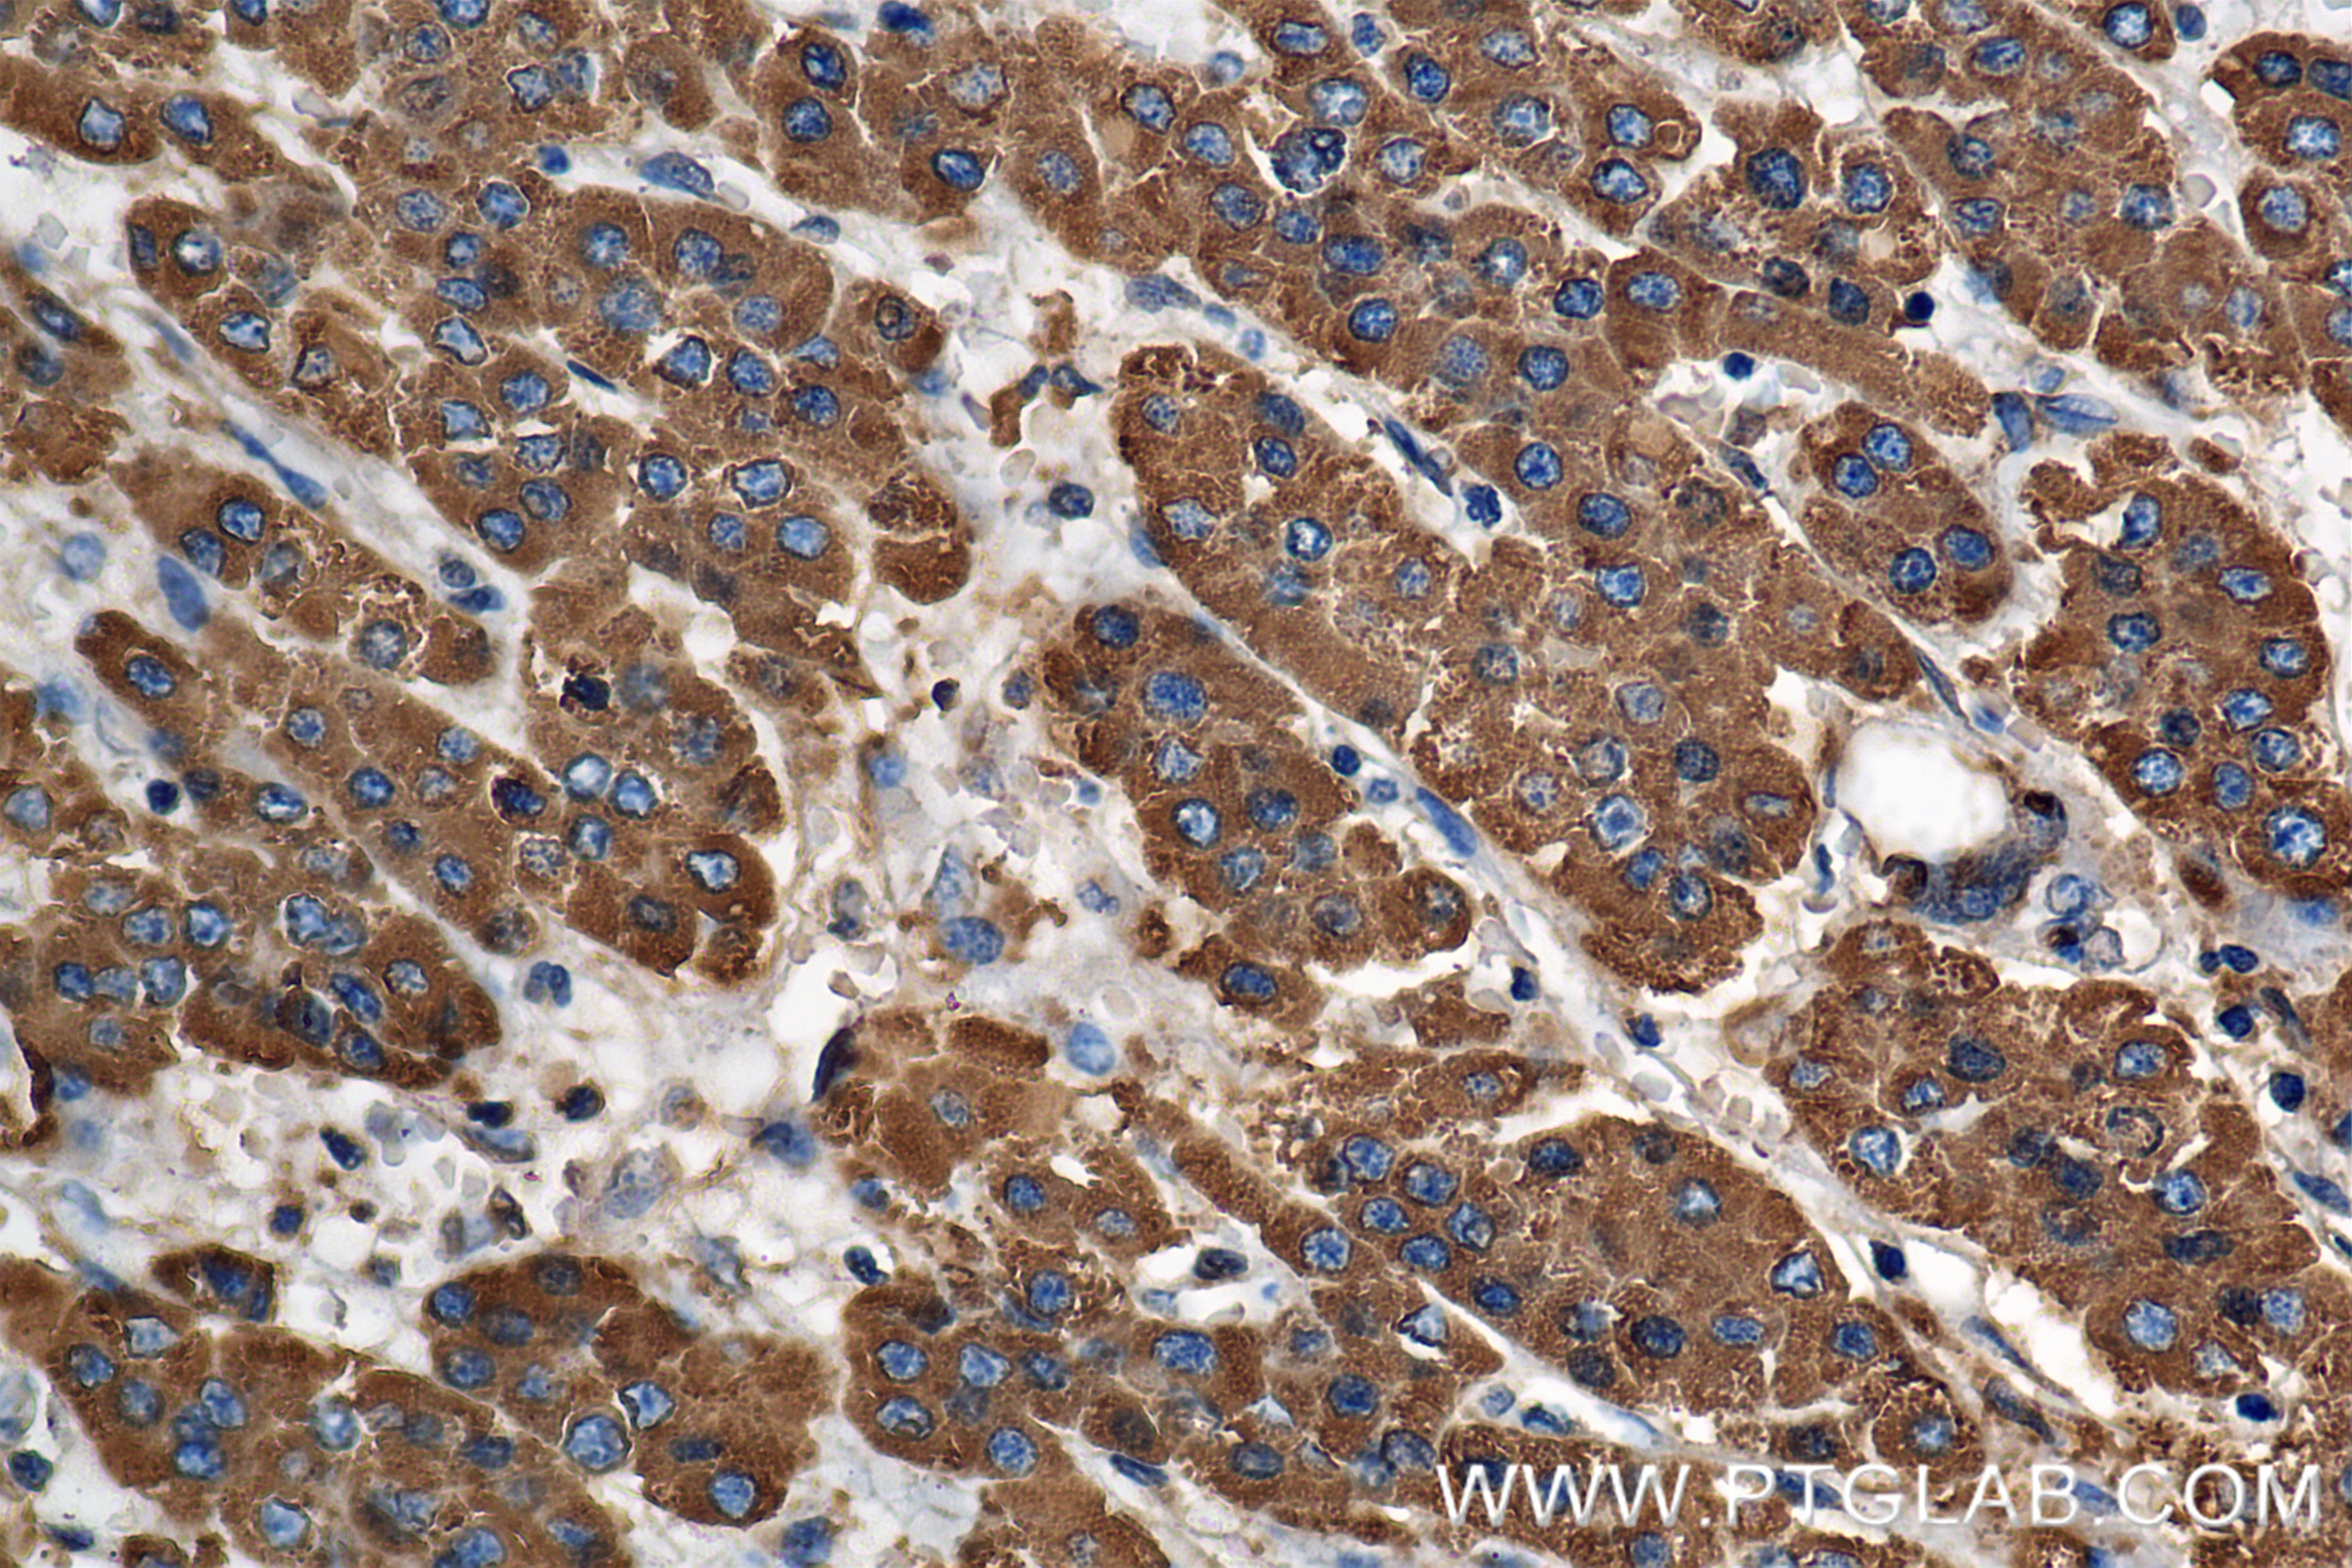
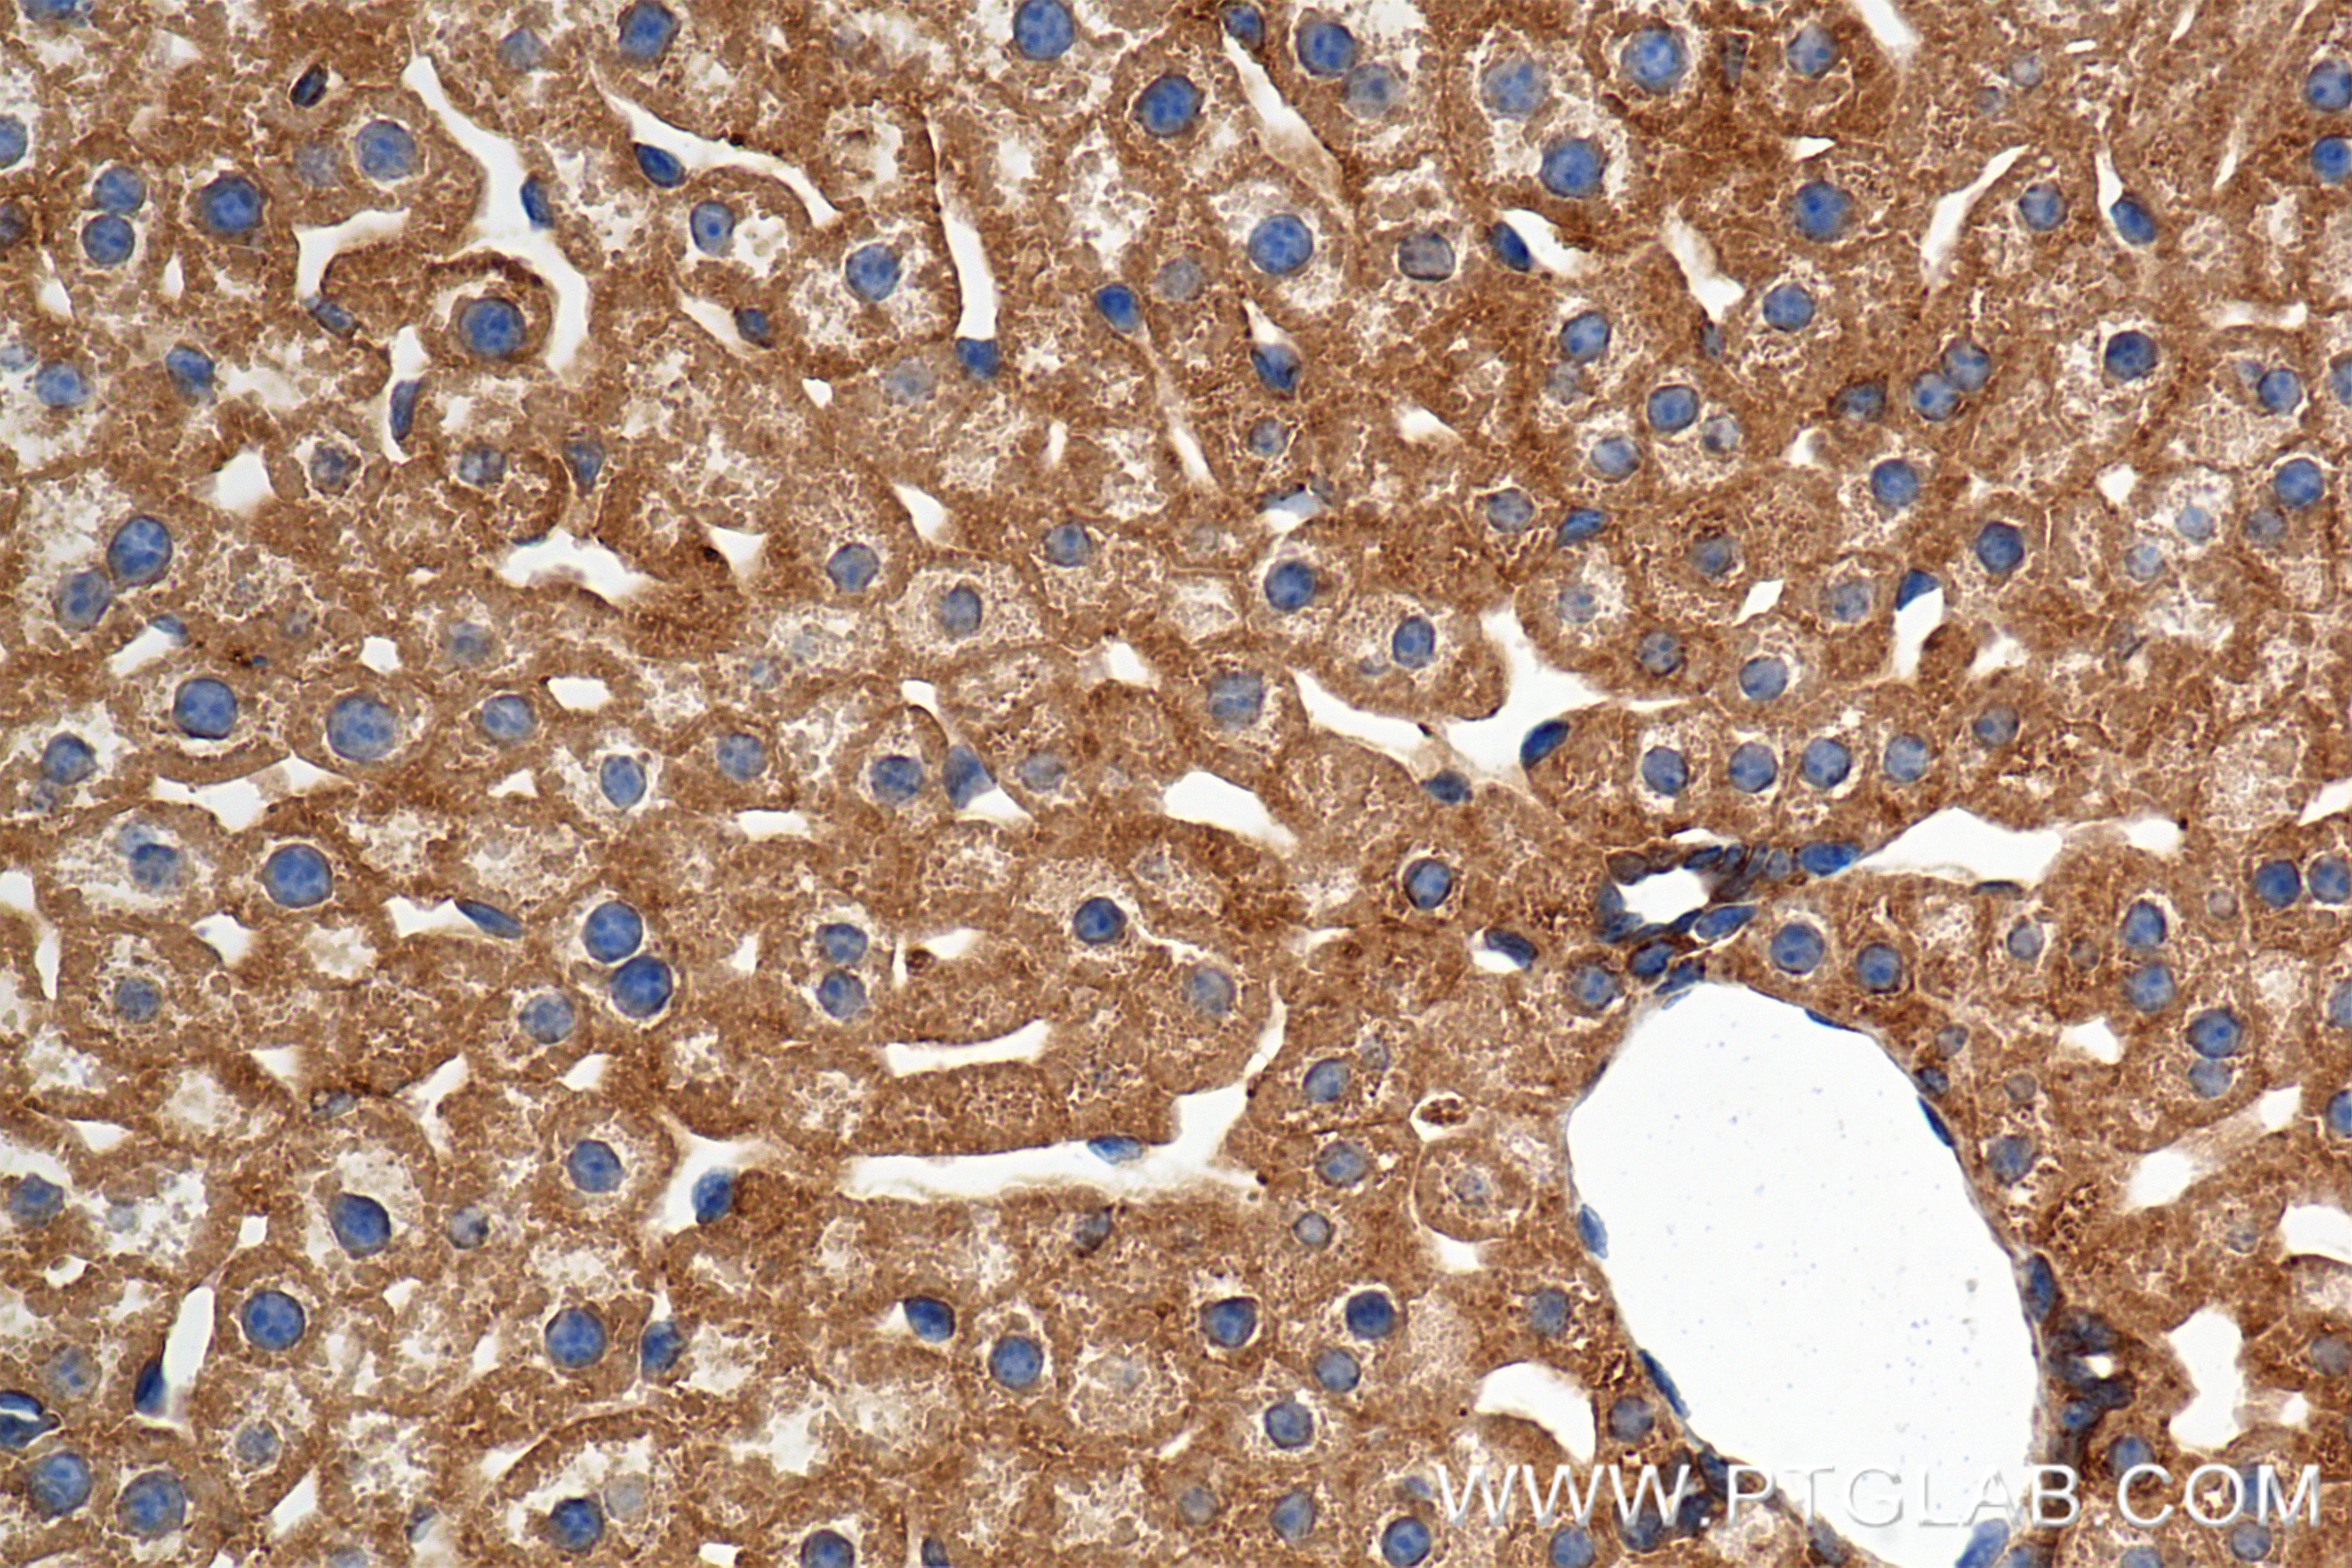
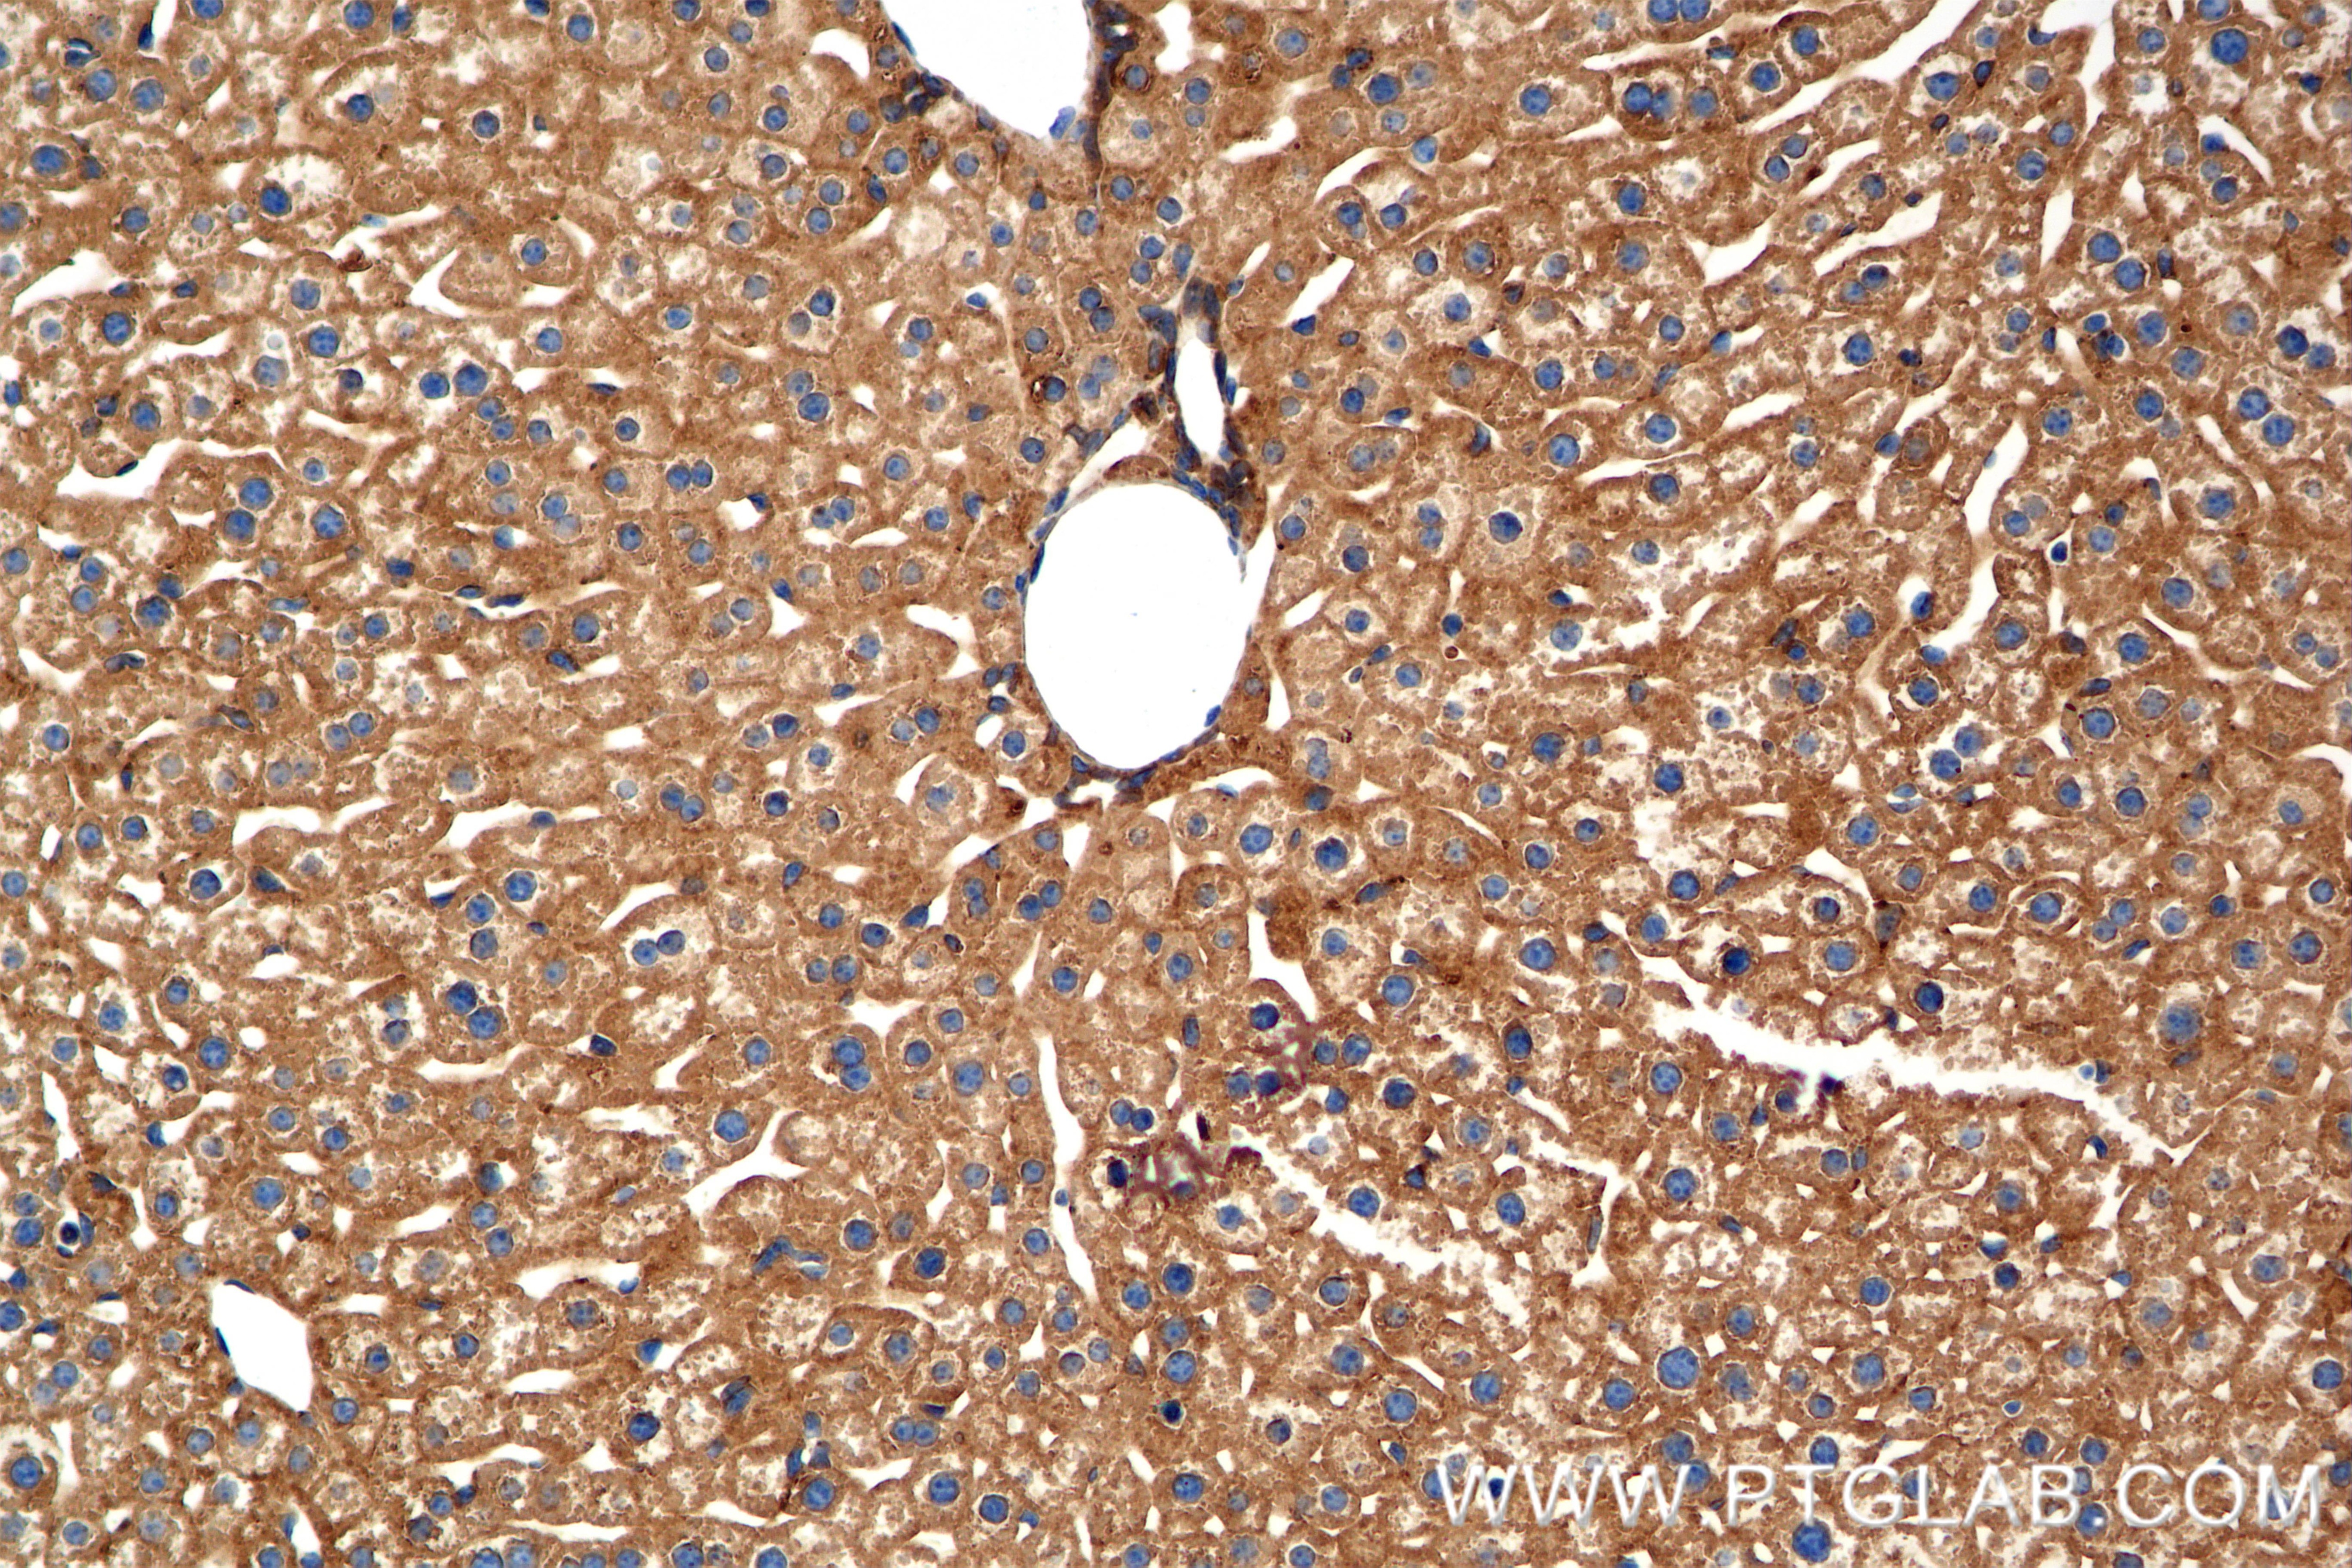

Tested Applications
| Positive WB detected in | HepG2 cells, A375 cells, HEK-293 cells, HuH-7 cells, mouse liver tissue, rat liver tissue |
| Positive IHC detected in | human hepatocellular cancer, mouse liver tissue Note: suggested antigen retrieval with TE buffer pH 9.0; (*) Alternatively, antigen retrieval may be performed with citrate buffer pH 6.0 |
| Positive IF-P detected in | mouse kidney tissue |
| Positive IF-Fro detected in | mouse kidney tissue |
Recommended dilution
| Application | Dilution |
|---|---|
| Western Blot (WB) | WB : 1:1000-1:4000 |
| Immunohistochemistry (IHC) | IHC : 1:200-1:800 |
| Immunofluorescence (IF)-P | IF-P : 1:50-1:500 |
| Immunofluorescence (IF)-FRO | IF-FRO : 1:50-1:500 |
| It is recommended that this reagent should be titrated in each testing system to obtain optimal results. | |
| Sample-dependent, Check data in validation data gallery. | |
Product Information
86193-1-RR targets ANGPTL3 in WB, IHC, IF-P, IF-Fro, ELISA applications and shows reactivity with human, mouse, rat samples.
| Tested Reactivity | human, mouse, rat |
| Host / Isotype | Rabbit / IgG |
| Class | Recombinant |
| Type | Antibody |
| Immunogen |
CatNo: Ag2573 Product name: Recombinant human ANGPTL3 protein Source: e coli.-derived, PGEX-4T Tag: GST Domain: 241-460 aa of BC058287 Sequence: GIPAECTTIYNRGEHTSGMYAIRPSNSQVFHVYCDVISGSPWTLIQHRIDGSQNFNETWENYKYGFGRLDGEFWLGLEKIYSIVKQSNYVLRIELEDWKDNKHYIEYSFYLGNHETNYTLHLVAITGNVPNAIPENKDLVFSTWDHKAKGHFNCPEGYSGGWWWHDECGENNLNGKYNKPRAKSKPERRRGLSWKSQNGRLYSIKSTKMLIHPTDSESFE Predict reactive species |
| Full Name | angiopoietin-like 3 |
| Calculated Molecular Weight | 460 aa, 54 kDa |
| Observed Molecular Weight | 54 kDa |
| GenBank Accession Number | BC058287 |
| Gene Symbol | ANGPTL3 |
| Gene ID (NCBI) | 27329 |
| Conjugate | Unconjugated |
| Form | Liquid |
| Purification Method | Protein A purification |
| UNIPROT ID | Q9Y5C1 |
| Storage Buffer | PBS with 0.02% sodium azide and 50% glycerol, pH 7.3. |
| Storage Conditions | Store at -20°C. Stable for one year after shipment. Aliquoting is unnecessary for -20oC storage. 20ul sizes contain 0.1% BSA. |
Background Information
ANGPTL3 belongs to the angiopoietin-like protein family. ANGPTL3 is mainly synthesized by liver cells and is notably expressed in kidney podocytes. Accumulating evidences have revealed that ANGPTL3 plays a critical role in both biological processes, such as lipid metabolism, angiogenesis and haematopoietic function and pathological changes, including atherosclerosis, carcinogenesis, nephrotic syndrome, diabetes, liver diseases and so on. Thus, ANGPTL3 may serve as a potential biomarker in these diseases.
Protocols
| Product Specific Protocols | |
|---|---|
| IF protocol for ANGPTL3 antibody 86193-1-RR | Download protocol |
| IHC protocol for ANGPTL3 antibody 86193-1-RR | Download protocol |
| WB protocol for ANGPTL3 antibody 86193-1-RR | Download protocol |
| Standard Protocols | |
|---|---|
| Click here to view our Standard Protocols |